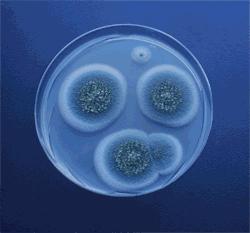
这些细胞害死了主人之后，又在实验室里繁殖了18000代
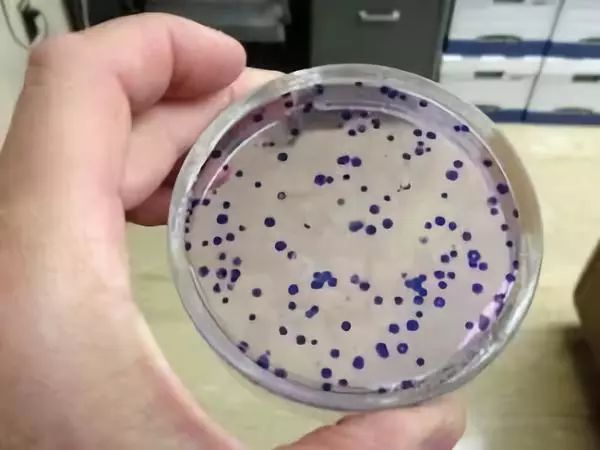
这些细胞害死了主人之后，又在实验室里繁殖了18000代

如果你突然得知那位因病去世了60多年的长辈其实还“活着”,并且在全世界的实验室里被研究,至今繁殖了18000代,总重量达到5000万吨,你会作何感想?
一位黑人妇女67年前患上宫颈癌去世,她的癌细胞却流传了下来做科学研究。
而她的家人与子孙在她死后20年,才知道举世闻名的海拉细胞原来是自己的“亲戚”。

细胞分裂
癌细胞一旦在体内找到了合适的落点“定居”下来,灾难就降临了。
它凭借顽强的生存能力和无限繁殖的特点在身体各个部位扩散蔓延和制造伤害。
虽然在生物体内威风凛凛,几乎无懈可击。
但如果把它取出体外培养基中培养,它又变成孱弱的“懦夫”,通常不出两天就死亡。
因此以前很难对癌细胞进行深入具体的科学研究,人类也只得任由癌细胞百般折磨而无计可施。
直到海拉细胞的出现,人类才打破了对癌细胞固有的厌恶与恐惧。
这种在体外也能无限繁殖的永生癌细胞,偶然间开创了生物学科新领域的研究。
它是人类与肿瘤这场世纪大战中我方的俘虏,成为助力科学研究的功臣,但同时也引发了不少伦理争论。

在当今时代,医生暗自取用癌症病人的细胞是违规的,指不定又得进一步激化医患关系。
但在上世纪50年代的美国,收集病人的细胞是合法的,而且没有征求病人及家属同意的习惯。
也多亏了乔治·盖医生一次擅自主张地将病人的奇特癌细胞留了下来,才有如今研究价值巨大的海拉细胞系。

乔治·盖医生
盖一直苦心试图在实验室中培养人体细胞,但就连顽强的普通癌细胞也无法试验成功。
直到一位非裔美国*草烟**农妇女——海莉耶塔·拉克斯住进了他所在的医院,成为他的病人。
怀着第五个孩子的拉克斯阴道流血异常,疼痛难熬。

Henrietta Lacks
世代都是*草烟**农出身,家境贫穷的她并没有闲钱和时间到医院就诊。
后来了解到约翰霍普金斯医院可以免费为贫困的非裔美国人治病,才动身前往。
但幸运之神没有降临到这位悲惨的妇人身上,检验发现拉克斯已经是宫颈癌*晚期。
*注:宫颈癌主要是由于人类乳突病毒(HPV)长期慢性感染子宫颈上皮细胞,细胞癌化导致的癌症。另外,抽烟、常用避孕药、多重*伴侣性**、不安全*行为性**等也是诱发宫颈癌的危险因子。

宫颈癌病变示意图
拉克斯从入院检验之时就受到了盖的高度关注。
因为她的肿瘤形态与一般的宫颈癌肿瘤有着很显著的差异。
通常宫颈癌肿瘤呈现像菜花一样不平整的形貌。
但拉克斯的肿瘤却像个紫色的葡萄一样光滑,稍微一碰就会出血。
而令人奇怪的是,在三个月前,她才带着这个“紫葡萄”完成了分娩。

免疫细胞大战癌细胞
和大部分罹患宫颈癌的病人一样,拉克斯也接受了放射治疗。
放疗是利用高能波照射肿瘤,实现杀死癌细胞的目的。
这种方法能维持人体其他器官组织的基本形态和机能,而且在癌症早期具有高达90%的治愈率。

装满放射性镭的试管被插入拉克斯的子宫颈,并缝合了起来。
尽管对拉克斯采取了一系列拯救措施,但还是抵不住癌细胞的侵略与扩散。
这个可怜的妇女最终难逃癌症的魔爪,去世了。
但她又不算真正意义上的死亡,因为在她不知情的情况下,她的活体细胞被悄悄保留了下来。

出于医学研究者的本能,盖禁不住对这种奇特癌细胞产生了强烈的好奇心。
于是在拉克斯镭射放疗手术的过程中,他除了完成手术,还多做了一件事。
他取了一些癌细胞组织,带到自己的实验室进行培养。
他猜想这一次,长期处于瓶颈的体外细胞培养实验也许可以取得突破性进展。
果不其然,拉克斯的癌细胞没有让他失望。
在培养的第二天,它们就出现了生长的迹象。
随后,细胞以惊人的速度繁殖生长,每24小时数量就翻一番。
研究癌细胞培养30多年来一直无法攻克的难关终于守得云开见月明。

海拉细胞增殖分裂
盖及其团队很快就激动地在电视节目中向大众公布他们的发现成果。
他们取拉克斯名字的缩写为这种细胞命名为“海拉细胞(Hela cell)”。
但没过多久,让科学家们欣喜若狂的海拉细胞彻底吞噬了拉克斯的生命。
而全世界的观众,包括拉克斯和她的家人在内,都不知道海拉细胞原来就取自这位悲惨的黑人烟农妇女身上的癌细胞。

拉克斯和她的丈夫大卫
欣喜过后科学家们惊异于海拉细胞奇特的性质,争相投入研究。
而由于海拉细胞繁殖和生存能力极强,它的子代很快被瓜分到世界各地的实验室中。
截止至2009年,全世界已经有超过6万篇论文基于海拉细胞的研究。

海拉细胞风靡全球科学界,引来无数人的关注与聚焦。
但直到拉克斯死后20年,科学家找到她的后代希望抽取他们的少量血液用作实验,被蒙在鼓里的拉克斯后代才醒悟当年昏暗的手术室里发生的一切。
他们起初是对当时医生医德缺乏和擅自主张行为的气愤、恼怒,而后也只能无奈接受。
实际上当时拉克斯本人也对此毫不知情。

拉克斯的后代
和其它癌细胞一样,海拉细胞也是由正常细胞癌变得来,具有错误填充的基因组。
正常人体细胞中含有46条染色体,而经过突变的癌细胞染色体数目多达76~80条。
这是因为基因组中出现未检测到的细胞分裂时发生错误累积。
它们异于常态细胞地表现为增殖速度激增,同时在人体内逃避了细胞凋亡。
但海拉细胞的增殖速度还要比普通的癌细胞更快。
错误是一种很奇妙的东西,扰乱了正常秩序,却成为癌细胞赖以生存的凭借。

染色体分离错误直接造成的数目异常是突变癌细胞的诱因
海拉细胞又不沦为普通细胞,在体外的培养环境中也丝毫不影响它的繁殖与生长。
这都得归功于它过度活化的端粒酶*。
普通细胞在每次增殖后端粒酶的长度会有所损失。
通常增殖约50次后细胞端粒酶无法继续使用,达到海佛列克极限。
细胞随即进入程序性死亡。
而海拉细胞突变出了一个超能力:它的端粒酶不会因增殖而减短。
因此它能够无限制地增殖生长,实现人类羡慕的“永生”。
*注:一种以自身RNA作为DNA复制模版,合成DNA序列的逆转录酶。

RNA逆转录示意图
在人类对癌细胞的漫漫探索之路上,海拉细胞作为第一个实现在体外永生培育成功的人源细胞,可谓功不可没。
打探清楚癌细胞的生长机理之后,接下来人类扭转局势,反而利用起海拉细胞的优势来深入研究其它病症。
在拉克斯去世的那个冬天,美国就爆发了一场骇人听闻的小儿麻痹症疫情。

小儿麻痹症患者步态蹒跚
而海拉细胞让当时的科学家看到了一线希望。
他们用诱发小儿麻痹症的脊髓灰质炎病毒感染海拉细胞。
惊喜的是,病毒在海拉细胞中极易存活,而且在培养基中培育更便于研究观察。
他们进而观测感染后细胞的形态变化,从中找到突破口,研发了小儿麻痹症疫苗。
迄今为止,小儿麻痹症疫苗已经预防了超过65万起死亡案例,还降低了1300人患上终身麻痹的风险。

由于海拉细胞生命力十分顽强,科学家们大胆地在它身上开展了许多已有构想的实验。
1954年科学家发明了一种分离单一细胞的方法,而后成功克隆海拉细胞。
这是人类第一次实现细胞克隆。
之后震惊全世界的著名克隆“多莉羊”也是以此为基础完成的。

克隆羊多莉
1956年,在人类还没有踏足太空的时候,海拉细胞就先人一步搭上前苏联的卫星畅游宇宙了。
当然,它们可不是单纯地去逛逛,而是肩负着生物科学研究的艰巨任务。
后来科学家发现,海拉细胞在太空中的繁殖速度更快。
也许地球已经不能满足海拉细胞的生活,太空才是它的归属吧。

搭载海拉细胞上太空的航天器
结核病、基因混合、HPV疫苗、原*弹子**爆炸对人体影响等研究过程中,也都能看见海拉细胞的踪影,而且还有着举足轻重的地位。
巨大的科研价值也推动着它往商业化的方向发展。
美国就有一家专门出售海拉细胞的公司,周产量多达6万亿个细胞,每瓶售价达到约250美元。
而丰厚的利润却与拉克斯的后代一点关系都没有,他们依旧忍受着贫困。

拉克斯已经逝去,而她的细胞却遍及世界各地。
实验室里将她的细胞群最大限度地加以研究利用。
人类生物学的不断发展,有这位悲惨的黑人烟农妇女的一份功劳。
虽然她到死的那一天都不知道,也想不到致使自己死亡的细胞会有这么大的效用。
而她的后代则面临着家族细胞基因被暴露的隐私泄露问题。

海拉细胞使人类科学受益半个多世纪,得到了许多歌颂与赞美。
人们却很容易遗忘这是海莉耶塔·拉克斯用生命代价换来的成果。
有的人死了,但她真的还活着,而且是永生。
*参考资料
Hela. Wikipedia.
Xavier Faussadier. HeLa cells: Origin ofthis important cell line in life science research. Being bio-reactive. 2017.
Khan F A. The Immortal Life of HenriettaLacks[J]. Journal of Ima, 2011, 43(2):93-94.
SHANNA FREEMAN. How Hela Cells Work. How stuffworks.
Joanna Moorhead. Henrietta Lacks: the motherof modern medicine. Medical research. 2010.
胡培菱. 海拉细胞的种族与道德争议,一段光荣又丑陋的医疗史. 2018.